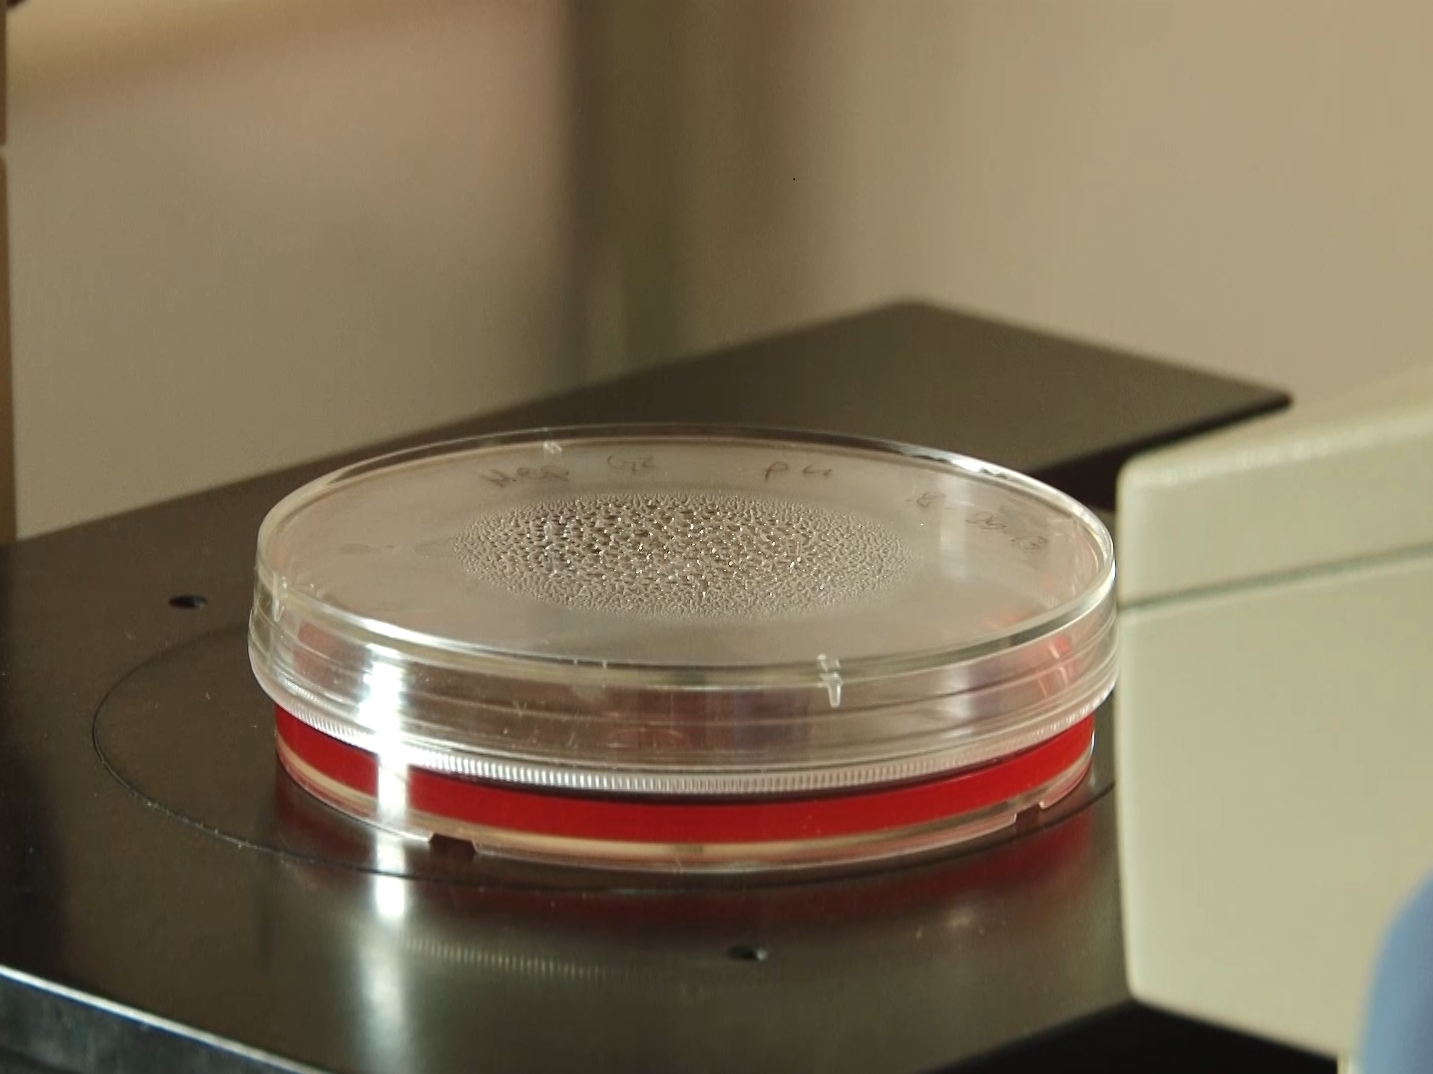

Naukowcy z Finlandii wykazali, że niektóre szczepy bakterii Desulfovibrio mogą być prawdopodobną przyczyną rozwoju choroby Parkinsona. Jeśli odkrycie się potwierdzi, będzie można opracować badania screeningowe nosicieli szczepów Desulfovibrio i stworzyć mechanizmy pozwalające na usunięcie tych bakterii z jelit. Typowane są do tego wirusy oraz modele postępowania żywieniowego.
– Już wcześniej wśród badaczy pojawiały się głosy o istnieniu toksyny lub bakterii wytwarzającej toksyny, które prowadzą do rozwoju choroby, przy czym w początkowym okresie, nawet przez pierwszych 10 lat, objawia się ona przewlekłymi zaparciami, a dopiero później, gdy mózg jest już uszkodzony, pojawiają się zaburzenia układu ruchu. Logiczne zatem było podjęcie badań nad wpływem omawianych bakterii na agregację alfa-synukleiny – wyjaśnia w komentarzu dla agencji Newseria Innowacje Per Saris, profesor mikrobiologii z Katedry Mikrobiologii na Wydziale Rolnictwa i Leśnictwa Uniwersytetu Helsińskiego.
Celem fińskiej grupy badawczej było zbadanie, czy wykryte u pacjentów szczepy bakterii Desulfovibrio mogą być czynnikiem indukującym chorobę Parkinsona. W ramach badania pobrano próbki kału 10 pacjentów z chorobą Parkinsona i ich zdrowych współmałżonków. Po wykryciu bakterii przeprowadzono ich izolację. Wyizolowane szczepy Desulfovibrio zastosowano jako pokarm do karmienia nicieni Caenorhabditis elegans, które posłużyły za organizmy modelowe. Okazało się, że szczepy rzeczywiście powodują istotną agregację białka alfa-synukleiny, a to ono determinuje powstawanie m.in. choroby Parkinsona. Naukowcy odkryli też, że te same szczepy, wyizolowane od zdrowych osób, nie powodują agregacji alfa-synukleiny w takim samym stopniu.
– Obecnie możemy więc powiedzieć, że bakterie te znajdują się na czele listy czynników podejrzanych o inicjowanie rozwoju choroby Parkinsona – wskazuje prof. Per Saris. – Występują one powszechnie w glebie, wodzie i odchodach zwierząt. Wszyscy mamy z nimi styczność poprzez jedzenie, picie i kontakt z otoczeniem. Ich metabolizm charakteryzuje się tym, że jego produktem jest siarkowodór. Bakterie te mogą wpływać na wytwarzanie magnetytu, a istotnym czynnikiem są również ich dehydrogenazy.
Jak podkreślają naukowcy, wskutek stanu zapalnego spada skuteczność organizmu do neutralizowania siarkowodoru, co może wpływać na rozwój choroby Parkinsona u nosicieli bakterii. Znaczenie mogą mieć też cząsteczki greigitu lub supermagnetyczne cząsteczki, również produkowane przez bakterie Desulfovibrio, a także lipopolisacharydy tych bakterii, które wywołują stan zapalny.
– Nie można wykluczyć też innych czynników. Potrzebne są kolejne badania – podkreśla naukowiec z Uniwersytetu Helsińskiego. – Wyniki naszych prac mogą wskazywać na potrzebę badań przesiewowych w kierunku obecności dużych populacji bakterii Desulfovibrio. U pacjentów, u których stwierdzono ten problem, można by wówczas wdrażać leczenie eradykacyjne, aby zapobiec wystąpieniu choroby Parkinsona albo spowolnić jej postęp. Jak dotąd jednak nie ma żadnych badań na temat skuteczności tych rozwiązań. Mamy nadzieję, że nasze prace będą stanowić bodziec do dalszych badań.
Badacze z Uniwersytetu Helsińskiego, aby potwierdzić słuszność swojego odkrycia, prowadzą obecnie eksperymenty na myszach, które są bardziej zbliżone genetycznie do człowieka niż nicienie. Na podstawie badań mutacji i porównania genomu starają się ustalić mechanizm inicjowania choroby przez bakterie Desulfovibrio. Poszukują również wirusów, które je zabijają, a także bakterii i pokarmów działających na nie hamująco.
![laboratorium-mikroskop-foto_1 Naukowcy odkryli bakterie, które mogą być odpowiedzialne za rozwój choroby Parkinsona. Trwają prace nad potwierdzeniem odkrycia [DEPESZA]](https://www.piekny.pl/wp-content/uploads/2023/06/laboratorium-mikroskop-foto_1-1020x600.png)











